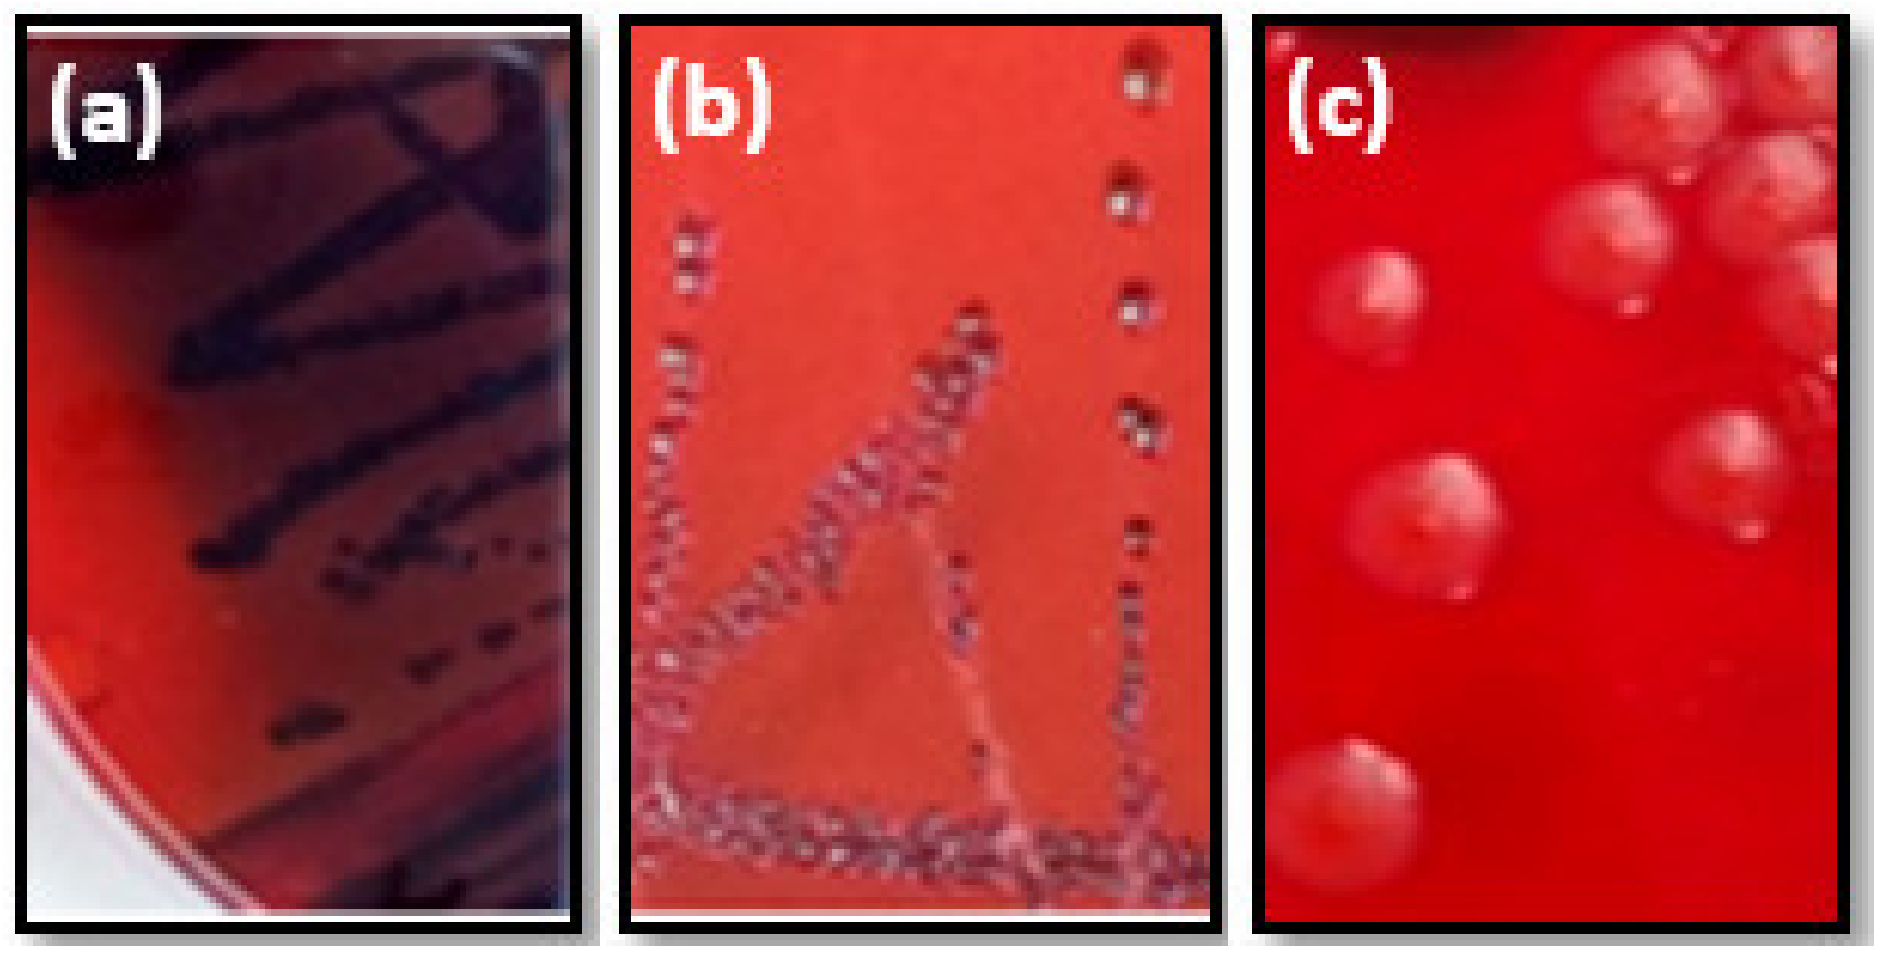

Detection of Methicillin-Resistant Staphylococcus aureus among Foodborne Pathogenic Strains and Assessment of Their Adhesion Ability and Cytotoxic Effects in HCT-116 Cells
Abstract
1. Introduction
2. Materials and Methods
2.1. Bacterial Strains
2.2. Susceptibility to Antibiotics
2.3. Detection of Methicillin Resistance Gene
2.4. Adhesive Abilities of Tested Strains
2.5. Hydrophobicity of Bacterial Cell Surfaces
2.6. Secretion of Exo-Enzymes Hemolysins
2.7. Cytotoxicity on HCT116 Cells
2.8. Oxidative Status Evaluation
2.9. Mitochondrial Membrane Potential (MMP) Assay
2.10. Statistical Analyses
3. Results
3.1. Susceptibility Profiles of S. aureus Strains and PCR- Detection of mecA Gene
3.2. Adhesive Properties of Tested Strains
3.3. Hemolysin and Hydrolytic Enzymes Production
3.4. Toxicity in HCT116 Cells
3.5. ROS Generation in Infected Cells
3.6. Loss of Mitochondrial Transmembrane Potential
4. Discussion
5. Conclusions
Author Contributions
Funding
Data Availability Statement
Acknowledgments
Conflicts of Interest
References
- Lakhundi, S.; Zhang, K. Methicillin-Resistant Staphylococcus aureus: Molecular Characterization, Evolution, and Epidemiology. Clin. Microbiol. Rev. 2018, 31, e00020-18. [Google Scholar] [CrossRef]
- Diekema, D.J.; Pfaller, M.A.; Schmitz, F.J.; Smayevsky, J.; Bell, J.; Jones, R.N.; Beach, M.; SENTRY Partcipants Group. Survey of infections due to Staphylococcus species: Frequency of occurrence and antimicrobial susceptibility of isolates collected in the United States, Canada, Latin America, Europe, and the Western Pacific region for the SENTRY Antimicrobial Surveillance Program, 1997–1999. Clin. Infect. Dis. 2001, 32 (Suppl. S2), S114–S132. [Google Scholar]
- Romero, L.C.; de Souza da Cunha, M.L.R. Insights into the epidemiology of community-associated methicillin-resistant Staphylococcus aureus in special populations and at the community-healthcare interface. Braz. J. Infect. Dis. 2021, 25, 101636. [Google Scholar] [CrossRef]
- Pu, S.; Han, F.; Ge, B. Isolation and Characterization of Methicillin-Resistant Staphylococcus aureus Strains from Louisiana Retail Meats. Appl. Environ. Microbiol. 2009, 75, 265–267. [Google Scholar] [CrossRef]
- Kluytmans, J.A. Methicillin-resistant Staphylococcus aureus in food products: Cause for concern or case for complacency? Clin. Microbiol. Infect. 2010, 16, 11–15. [Google Scholar] [CrossRef]
- Chairat, S.; Gharsa, H.; Lozano, C.; Gómez-Sanz, E.; Gómez, P.; Zarazaga, M.; Boudabous, A.; Torres, C.; Ben Slama, K. Characterization of Staphylococcus aureus from Raw Meat Samples in Tunisia: Detection of Clonal Lineage ST398 from the African Continent. Foodborne Pathog. Dis. 2015, 12, 686–692. [Google Scholar] [CrossRef]
- Otto, M. Staphylococcal Biofilms. Microbiol. Spectr. 2018, 6, 4. [Google Scholar] [CrossRef]
- Thurlow, L.R.; Hanke, M.L.; Fritz, T.; Angle, A.; Aldrich, A.; Williams, S.H.; Engebretsen, I.L.; Bayles, K.W.; Horswill, A.R.; Kielian, T. Staphylococcus aureus Biofilms Prevent Macrophage Phagocytosis and Attenuate Inflammation In Vivo. J. Immunol. 2011, 186, 6585–6596. [Google Scholar] [CrossRef]
- Foster, T.J. The MSCRAMM Family of Cell-Wall-Anchored Surface Proteins of Gram-Positive Cocci. Trends Microbiol. 2019, 27, 927–941. [Google Scholar] [CrossRef]
- Cheung, G.Y.C.; Bae, J.S.; Otto, M. Pathogenicity and virulence of Staphylococcus aureus. Virulence 2021, 12, 547–569. [Google Scholar] [CrossRef]
- Hennekinne, J.A.; De Buyser, M.L.; Dragacci, S. Staphylococcus aureus and its food poisoning toxins: Characterization and outbreak investigation. FEMS Microbiol. Rev. 2012, 36, 815–836. [Google Scholar] [CrossRef]
- Hu, D.-L.; Li, S.; Fang, R.; Ono, H.K. Update on molecular diversity and multipathogenicity of staphylococcal superantigen toxins. Anim. Dis. 2021, 1, 7. [Google Scholar] [CrossRef]
- Kong, C.; Neoh, H.-M.; Nathan, S. Targeting Staphylococcus aureus Toxins: A Potential form of Anti-Virulence Therapy. Toxins 2016, 8, 72. [Google Scholar] [CrossRef]
- Fisher, E.L.; Otto, M.; Cheung, G.Y.C. Basis of Virulence in Enterotoxin-Mediated Staphylococcal Food Poisoning. Front. Microbiol. 2018, 9, 436. [Google Scholar] [CrossRef]
- Ahmad-Mansour, N.; Loubet, P.; Pouget, C.; Dunyach-Remy, C.; Sotto, A.; Lavigne, J.-P.; Molle, V. Staphylococcus aureus Toxins: An Update on Their Pathogenic Properties and Potential Treatments. Toxins 2021, 13, 677. [Google Scholar] [CrossRef]
- Llewelyn, M.; Cohen, J. Superantigens: Microbial agents that corrupt immunity. Lancet Infect. Dis. 2002, 2, 156–162. [Google Scholar] [CrossRef]
- Deplanche, M.; Mouhali, N.; Nguyen, M.-T.; Cauty, C.; Ezan, F.; Diot, A.; Raulin, L.; Dutertre, S.; Langouet, S.; Legembre, P.; et al. Staphylococcus aureus induces DNA damage in host cell. Sci. Rep. 2019, 9, 7694. [Google Scholar] [CrossRef]
- Pizzino, G.; Irrera, N.; Cucinotta, M.; Pallio, G.; Mannino, F.; Arcoraci, V.; Squadrito, F.; Altavilla, D.; Bitto, A. Oxidative Stress: Harms and Benefits for Human Health. Oxid. Med. Cell. Longev. 2017, 2017, 8416763. [Google Scholar] [CrossRef]
- Cathcart, R.; Schwiers, E.; Ames, B.N. Detection of picomole levels of hydroperoxides using a fluorescent dichlorofluorescein assay. Anal. Biochem. 1983, 134, 111–116. [Google Scholar] [CrossRef]
- Debbasch, C.; Brignole, F.; Pisella, P.J.; Warnet, J.M.; Rat, P.; Baudouin, C. Quaternary ammoniums and other preservatives’ contribution in oxidative stress and apoptosis on Chang conjunctival cells. Investig. Opthalmology Vis. Sci. 2001, 42, 642–652. [Google Scholar]
- Gomes, A.; Fernandes, E.; Lima, J.L.F.C. Fluorescence probes used for detection of reactive oxygen species. J. Biochem. Biophys. Methods 2005, 65, 45–80. [Google Scholar] [CrossRef] [PubMed]
- Dayem, A.A.; Hossain, M.K.; Lee, S.B.; Kim, K.; Saha, S.K.; Yang, G.-M.; Choi, H.Y.; Cho, S.-G. The Role of Reactive Oxygen Species (ROS) in the Biological Activities of Metallic Nanoparticles. Int. J. Mol. Sci. 2017, 18, 120. [Google Scholar] [CrossRef]
- Kaina, B. DNA damage-triggered apoptosis: Critical role of DNA repair, double-strand breaks, cell proliferation and signaling. Biochem. Pharmacol. 2003, 66, 1547–1554. [Google Scholar] [CrossRef]
- Geha, D.J.; Uhl, J.R.; Gustaferro, C.A.; Persing, D.H. Multiplex PCR for identification of methicillin-resistant staphylococci in the clinical laboratory. J. Clin. Microbiol. 1994, 32, 1768–1772. [Google Scholar] [CrossRef] [PubMed]
- Touati, A.; Achour, W.; Abbassi, M.S.; Ben Hassen, A. Détection des gènes ica et de la production de slime parmi des souches de Staphylococcus epidermidis isolées d’infections liées aux cathéters chez des patients neutropéniques [Detection of ica genes and slime production in a collection of Staphylococcus epidermidis strains from catheter-related infections in neutropenic patients]. Pathol. Biol. 2007, 55, 277–282. [Google Scholar] [PubMed]
- Mack, D.; Bartscht, K.; Fischer, C.; Rohde, H.; de Grahl, C.; Dobinsky, S.; Horstkotte, M.A.; Kiel, K.; Knobloch, J.K.-M. Genetic and biochemical analysis of Staphylococcus epidermidis biofilm accumulation. Methods Enzym. 2001, 336, 215–239. [Google Scholar] [CrossRef]
- Bellon-Fontaine, M.-N.; Rault, J.; van Oss, C. Microbial adhesion to solvents: A novel method to determine the electron-donor/electron-acceptor or Lewis acid-base properties of microbial cells. Colloids Surfaces B Biointerfaces 1996, 7, 47–53. [Google Scholar] [CrossRef]
- Abasolo-Pacheco, F.; Saucedo, P.E.; Mazón-Suástegui, J.M.; Tovar-Ramírez, D.; Araya, R.; Ramírez-Orozco, J.M.; Campa-Córdova, A.I. Isolation and use of beneficial microbiota from the digestive tract of lions-paw scallop Nodipecten subnodosus and winged pearl oyster Pteria sterna in oyster aquaculture. Aqua. Res. 2016, 47, 3042–3051. [Google Scholar] [CrossRef]
- Ben Kahla-Nakbi, A.; Chaieb, K.; Bakhrouf, A. Investigation of several virulence properties among Vibrio alginolyticus strains isolated from diseased cultured fish in Tunisia. Dis. Aquat. Org. 2009, 86, 21–28. [Google Scholar] [CrossRef]
- Stulik, L.; Malafa, S.; Hudcova, J.; Rouha, H.; Henics, B.Z.; Craven, D.E.; Sonnevend, A.M.; Nagy, E. α-Hemolysin Activity of Methicillin-Susceptible Staphylococcus aureus Predicts Ventilator-associated Pneumonia. Am. J. Respir. Crit. Care Med. 2014, 190, 1139–1148. [Google Scholar] [CrossRef]
- Saliba, A.M.; Filloux, A.; Ball, G.; Silva, A.S.V.; Assis, M.-C.; Plotkowski, M.-C. Type III secretion-mediated killing of endothelial cells by Pseudomonas aeruginosa. Microb. Pathog. 2002, 33, 153–166. [Google Scholar] [CrossRef] [PubMed]
- Murakami, J.; Kishi, K.; Hirai, K.; Hiramatsu, K.; Yamasaki, T.; Nasu, M. Macrolides and clindamycin suppress the release of Shiga-like toxins from Escherichia coli O157:H7 in vitro. Int. J. Antimicrob. Agents 2000, 15, 103–109. [Google Scholar] [CrossRef] [PubMed]
- Chen, T.; Wong, Y.-S. Selenocystine induces caspase-independent apoptosis in MCF-7 human breast carcinoma cells with involvement of p53 phosphorylation and reactive oxygen species generation. Int. J. Biochem. Cell Biol. 2009, 41, 666–676. [Google Scholar] [CrossRef] [PubMed]
- Gould, I. Costs of hospital-acquired methicillin-resistant Staphylococcus aureus (MRSA) and its control. Int. J. Antimicrob. Agents 2006, 28, 379–384. [Google Scholar] [CrossRef] [PubMed]
- Dinges, M.M.; Orwin, P.M.; Schlievert, P.M. Exotoxins of Staphylococcus aureus. Clin. Microbiol. Rev. 2000, 13, 16–34. [Google Scholar] [CrossRef]
- Borg, M.A.; Camilleri, L. What Is Driving the Epidemiology of Methicillin-Resistant Staphylococcus aureus Infections in Europe? Microb. Drug Resist. 2021, 27, 889–894. [Google Scholar] [CrossRef]
- Pereira, V.; Lopes, C.; Castro, A.; Silva, J.; Gibbs, P.; Teixeira, P. Characterization for enterotoxin production, virulence factors, and antibiotic susceptibility of Staphylococcus aureus isolates from various foods in Portugal. Food Microbiol. 2009, 26, 278–282. [Google Scholar] [CrossRef]
- Fuda, C.; Suvorov, M.; Vakulenko, S.B.; Mobashery, S. The Basis for Resistance to β-Lactam Antibiotics by Penicillin-binding Protein 2a of Methicillin-resistant Staphylococcus aureus. J. Biol. Chem. 2004, 279, 40802–40806. [Google Scholar] [CrossRef]
- Itou, T.; Katayama, Y.; Hiramatsu, K. A new mobile genetic element, staphylococcal cassette chromosome mec, encodes methicillin resistance in Staphylococcus aureus. Antimicrob. Agents Chemother. 2000, 55, 1549–1555. [Google Scholar]
- Schwendener, S.; Cotting, K.; Perreten, V. Novel methicillin resistance gene mecD in clinical Macrococcus caseolyticus strains from bovine and canine sources. Sci. Rep. 2017, 7, srep43797. [Google Scholar] [CrossRef]
- Harrison, E.M.; Paterson, G.K.; Holden, M.T.; Larsen, J.; Stegger, M.; Larsen, A.R.; Petersen, A.; Skov, R.L.; Christensen, J.M.; Bak Zeuthen, A.; et al. Whole genome sequencing identifies zoonotic transmission of MRSA isolates with the novel mecA homologue mecC. EMBO Mol. Med. 2013, 5, 509–515. [Google Scholar] [CrossRef] [PubMed]
- Szczuka, E.; Krzymińska, S.; Bogucka, N.; Kaznowski, A. Multifactorial mechanisms of the pathogenesis of methicillin-resistant Staphylococcus hominis isolated from bloodstream infections. Antonie Leeuwenhoek 2017, 111, 1259–1265. [Google Scholar] [CrossRef] [PubMed]
- Rachid, S.; Ohlsen, K.; Wallner, U.; Hacker, J.; Hecker, M.; Ziebuhr, W. Alternative transcription factor sigma(B) is involved in regulation of biofilm expression in a Staphylococcus aureus mucosal isolate. J. Bacteriol. 2000, 182, 6824–6826. [Google Scholar] [CrossRef] [PubMed]
- Silva, V.; Almeida, L.; Gaio, V.; Cerca, N.; Manageiro, V.; Caniça, M.; Capelo, J.L.; Igrejas, G.; Poeta, P. Biofilm Formation of Multidrug-Resistant MRSA Strains Isolated from Different Types of Human Infections. Pathogens 2021, 10, 970. [Google Scholar] [CrossRef] [PubMed]
- Sandasi, M.; Leonard, C.; Viljoen, A. The in vitro antibiofilm activity of selected culinary herbs and medicinal plants against Listeria monocytogenes. Lett. Appl. Microbiol. 2010, 50, 30–35. [Google Scholar] [CrossRef] [PubMed]
- Ballah, F.M.; Islam, M.S.; Rana, M.L.; Ferdous, F.B.; Ahmed, R.; Pramanik, P.K.; Karmoker, J.; Ievy, S.; Sobur, M.A.; Siddique, M.P.; et al. Phenotypic and Genotypic Detection of Biofilm-Forming Staphylococcus aureus from Different Food Sources in Bangladesh. Biology 2022, 11, 949. [Google Scholar] [CrossRef]
- Chen, Q.; Xie, S.; Lou, X.; Cheng, S.; Liu, X.; Zheng, W.; Zheng, Z.; Wang, H. Biofilm formation and prevalence of adhesion genes among Staphylococcus aureus isolates from different food sources. MicrobiologyOpen 2020, 9, e00946. [Google Scholar] [CrossRef]
- Krasowska, A.; Sigler, K. How microorganisms use hydrophobicity and what does this mean for human needs? Front. Cell. Infect. Microbiol. 2014, 4, 112. [Google Scholar] [CrossRef]
- Mirani, Z.A.; Fatima, A.; Urooj, S.; Aziz, M.; Khan, M.; Abbas, T. Relationship of cell surface hydrophobicity with biofilm formation and growth rate: A study on Pseudomonas aeruginosa, Staphylococcus aureus, and Escherichia coli. Iran. J. Basic Med. Sci. 2018, 21, 760–769. [Google Scholar] [CrossRef]
- Hamadi, F.; Latrache, H.; Mabrrouki, M.; Elghmari, A.; Outzourhit, A.; Ellouali, M.; Chtaini, A. Effect of pH on distribution and adhesion of Staphylococcus aureus to glass. J. Adhes. Sci. Technol. 2005, 19, 73–85. [Google Scholar] [CrossRef]
- Kouidhi, B.; Zmantar, T.; Hentati, H.; Bakhrouf, A. Cell surface hydrophobicity, biofilm formation, adhesives properties and molecular detection of adhesins genes in Staphylococcus aureus associated to dental caries. Microb. Pathog. 2010, 49, 14–22. [Google Scholar] [CrossRef] [PubMed]
- Lakshmi, H.P.; Prasad, U.V.; Yeswanth, S.; Swarupa, V.; Prasad, O.H.; Narasu, M.L.; Sarma, P.V.G.K. Molecular characterization of α-amylase from Staphylococcus aureus. Bioinformation 2013, 9, 281–285. [Google Scholar] [CrossRef] [PubMed]
- Shaw, L.; Golonka, E.; Potempa, J.; Foster, S.J. The role and regulation of the extracellular proteases of Staphylococcus aureus. Microbiology 2004, 150 Pt 1, 217–228. [Google Scholar] [CrossRef] [PubMed]
- Jaeger, K.-E.; Dijkstra, B.W.; Reetz, M.T. Bacterial Biocatalysts: Molecular Biology, Three-Dimensional Structures, and Biotechnological Applications of Lipases. Annu. Rev. Microbiol. 1999, 53, 315–351. [Google Scholar] [CrossRef]
- Castro, A.; Santos, C.; Meireles, H.; Silva, J.; Teixeira, P. Food handlers as potential sources of dissemination of virulent strains of Staphylococcus aureus in the community. J. Infect. Public Health 2016, 9, 153–160. [Google Scholar] [CrossRef]
- Amit, K.; Parimal, D.; Chandradipa, G. Biochemical and Molecular Analysis of Staphylococcus aureus Clinical Isolates from Hospitalized Patients. Can. J. Infect. Dis. Med. Microbiol. 2016, 2016, 9041636. [Google Scholar]
- Merghni, A.; Ben Nejma, M.; Helali, I.; Hentati, H.; Bongiovanni, A.; Lafont, F.; Aouni, M.; Mastouri, M. Assessment of adhesion, invasion and cytotoxicity potential of oral Staphylococcus aureus strains. Microb. Pathog. 2015, 86, 1–9. [Google Scholar] [CrossRef]
- Saïd-Salim, B.; Dunman, P.M.; McAleese, F.M.; Macapagal, D.; Murphy, E.; McNamara, P.J.; Arvidson, S.; Foster, T.J.; Projan, S.J.; Kreiswirth, B.N. Global Regulation of Staphylococcus aureus Genes by Rot. J. Bacteriol. 2003, 185, 610–619. [Google Scholar] [CrossRef]
- Hamdi, H.; Ben Salem, I.; Ben Othmène, Y.; Annabi, E.; Abid-Essefi, S. The involvement of ROS generation on Epoxiconazole-induced toxicity in HCT116 cells. Pestic. Biochem. Physiol. 2018, 148, 62–67. [Google Scholar] [CrossRef]
- Yu, J.-Y.; Zheng, Z.-H.; Son, Y.O.; Shi, X.; Jang, Y.-O.; Lee, J.-C. Mycotoxin zearalenone induces AIF- and ROS-mediated cell death through p53- and MAPK-dependent signaling pathways in RAW264.7 macrophages. Toxicol. In Vitro 2011, 25, 1654–1663. [Google Scholar] [CrossRef]
- Schwarzbacherová, V.; Wnuk, M.; Lewinska, A.; Potocki, L.; Zebrowski, J.; Koziorowski, M.; Holečková, B.; Šiviková, K.; Dianovský, J. Evaluation of cytotoxic and genotoxic activity of fungicide formulation Tango Super in bovine lymphocytes. Environ. Pollut. 2017, 220 Pt A, 255–263. [Google Scholar] [CrossRef]
- Cao, J.; Liu, Y.; Jia, L.; Zhou, H.M.; Kong, Y.; Yang, G.; Jiang, L.P.; Li, Q.J.; Zhong, L.F. Curcumin induces apoptosis through mitochondrial hyperpolarization and mtDNA damage in human hepatoma G2 cells. Free Radic. Biol. Med. 2007, 43, 968–975. [Google Scholar] [CrossRef] [PubMed]
- Wang, W.; Xiong, W.; Wan, J.; Sun, X.; Xu, H.; Yang, X. The decrease of PAMAM dendrimer-induced cytotoxicity by PEGylation via attenuation of oxidative stress. Nanotechnology 2009, 20, 105103. [Google Scholar] [CrossRef] [PubMed]
- Amengual, J.; Lobo, G.P.; Golczak, M.; Li, H.N.; Klimova, T.; Hoppel, C.L.; Wyss, A.; Palczewski, K.; von Lintig, J. A mitochondrial enzyme degrades carotenoids and protects against oxidative stress. FASEB J. 2011, 25, 948–959. [Google Scholar] [CrossRef] [PubMed]

| Code | P | FOX | CTX | K | TM | E | CMN | NORF | OFX | FAD | RIF | CHL | mecA |
|---|---|---|---|---|---|---|---|---|---|---|---|---|---|
| ATCC | S | S | S | S | S | S | S | S | S | S | S | S | − |
| 2595 | R | S | S | R | S | S | S | S | S | S | S | S | − |
| 1538 | R | S | S | S | S | S | S | S | S | S | S | S | − |
| 2834 | R | S | S | S | R | R | R | S | S | S | S | S | − |
| 896 | R | R | R | R | S | S | S | S | S | S | S | S | + |
| 853 | R | R | R | S | S | S | S | S | S | S | S | S | + |
| 2471 | R | S | S | S | S | S | S | S | S | S | S | S | − |
| 976′ | R | S | S | S | S | S | S | S | S | S | S | S | − |
| 977′ | R | S | S | S | S | S | S | S | S | S | S | S | − |
| 976″ | R | S | S | S | S | S | S | S | S | S | S | S | − |
| 977″ | R | S | S | S | S | S | S | S | S | S | S | S | − |
| % R | 100 | 20 | 20 | 20 | 10 | 10 | 10 | 0 | 0 | 0 | 0 | 0 | 20 |
| Code | Origin | Hydrophobicity | Slime Production | Biofilm Formation | |||
|---|---|---|---|---|---|---|---|
| % | State | Colonies | Phenotype | OD 570 nm | State | ||
| ATCC | - | 29 ± 1.4 | H. hydrophilic | Black | S(+) | 1.86 ± 0.32 | H.B.F |
| 2595 | Cake | 4.35 ± 0.06 | H. hydrophilic | Black | S(+) | 0.6 ± 0.14 | W.B.F |
| 1538 | Cake | 18.73 ± 0.11 | H. hydrophilic | Red | S(−) | 1.3 ± 0.31 | H.B.F |
| 2834 | Cheese | 7.78 ± 0.05 | H. hydrophilic | Red | S(−) | 0.3 ± 0.19 | W.B.F |
| 896 | Milk | 19.56 ± 0.36 | H. hydrophilic | Black | S(+) | 2.3 ± 0.02 | H.B.F |
| 853 | Milk | 16.03 ± 0.15 | H. hydrophilic | Red | S(−) | 0.6 ± 0.18 | W.B.F |
| 2471 | Sausage | 28.81 ± 0.34 | H. hydrophilic | Black | S(+) | 2.5 ± 0.08 | H.B.F |
| 976′ | Meat | 38.96 ± 45 | W. Hydrophobic | Red | S(−) | 0.2 ± 0.07 | W.B.F |
| 977′ | Meat | 18.50 ± 0.12 | H. hydrophilic | Red | S(−) | 0.3 ± 0.15 | W.B.F |
| 976″ | Chicken | 23.94 ± 0.3 | H. hydrophilic | Red | S(−) | 0.2 ± 0.05 | W.B.F |
| 977″ | Chicken | 28.50 ± 0.18 | H. hydrophilic | Red | S(−) | 1.5 ± 0.38 | H.B.F |
| Code | Origin | Lec | Cas | Lip | Amy | Gel | Hml |
|---|---|---|---|---|---|---|---|
| ATCC | − | + | + | + | + | + | β |
| 2595 | Cake | + | + | − | + | − | α |
| 1538 | Cake | + | + | + | + | − | β |
| 2834 | Cheese | + | + | − | + | − | γ |
| 896 | Milk | + | + | + | + | − | γ |
| 853 | Milk | + | + | + | + | − | β |
| 2471 | Sausage | + | + | + | + | − | β |
| 976′ | Meat | + | + | + | + | + | β |
| 977′ | Meat | + | + | + | + | + | β |
| 976″ | Chicken | + | + | + | + | + | β |
| 977″ | Chicken | + | + | + | + | + | β |
| % | 100 | 100 | 80 | 100 | 40 | 70 β |
Disclaimer/Publisher’s Note: The statements, opinions and data contained in all publications are solely those of the individual author(s) and contributor(s) and not of MDPI and/or the editor(s). MDPI and/or the editor(s) disclaim responsibility for any injury to people or property resulting from any ideas, methods, instructions or products referred to in the content. |
© 2023 by the authors. Licensee MDPI, Basel, Switzerland. This article is an open access article distributed under the terms and conditions of the Creative Commons Attribution (CC BY) license (https://creativecommons.org/licenses/by/4.0/).
Share and Cite
Merghni, A.; Hamdi, H.; Ben Abdallah, M.; Al-Hasawi, Z.M.; Al-Quwaie, D.A.; Abid-Essefi, S. Detection of Methicillin-Resistant Staphylococcus aureus among Foodborne Pathogenic Strains and Assessment of Their Adhesion Ability and Cytotoxic Effects in HCT-116 Cells. Foods 2023, 12, 974. https://doi.org/10.3390/foods12050974
Merghni A, Hamdi H, Ben Abdallah M, Al-Hasawi ZM, Al-Quwaie DA, Abid-Essefi S. Detection of Methicillin-Resistant Staphylococcus aureus among Foodborne Pathogenic Strains and Assessment of Their Adhesion Ability and Cytotoxic Effects in HCT-116 Cells. Foods. 2023; 12(5):974. https://doi.org/10.3390/foods12050974
Chicago/Turabian StyleMerghni, Abderrahmen, Hiba Hamdi, Marwa Ben Abdallah, Zaki M. Al-Hasawi, Diana A. Al-Quwaie, and Salwa Abid-Essefi. 2023. "Detection of Methicillin-Resistant Staphylococcus aureus among Foodborne Pathogenic Strains and Assessment of Their Adhesion Ability and Cytotoxic Effects in HCT-116 Cells" Foods 12, no. 5: 974. https://doi.org/10.3390/foods12050974
APA StyleMerghni, A., Hamdi, H., Ben Abdallah, M., Al-Hasawi, Z. M., Al-Quwaie, D. A., & Abid-Essefi, S. (2023). Detection of Methicillin-Resistant Staphylococcus aureus among Foodborne Pathogenic Strains and Assessment of Their Adhesion Ability and Cytotoxic Effects in HCT-116 Cells. Foods, 12(5), 974. https://doi.org/10.3390/foods12050974

